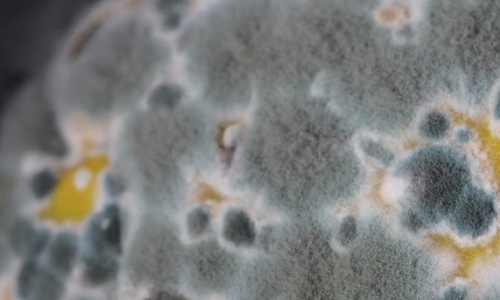
Cannabis Products May Harbor Fungal Toxins Harmful To Human Health, But Safety Regulations Are Uneven Or Nonexistent

Cannabis Products May Harbor Fungal Toxins Harmful To Human Health, But Safety Regulations Are Uneven Or Nonexistent
Cannabis News
April 10, 2024
Research Uncovers Potential Health Risks of Fungal Contaminants in Cannabis Products. Hemp and cannabis host many fungi inside and outside the plant, most of which are harmless to most people. However, certain types of fungi such as Aspergillus and Fusarium pose potential health concerns

Comments are closed, but trackbacks and pingbacks are open.